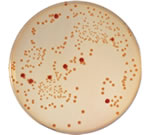

признаки кишечной палочки
Вопросы и ответы по: признаки кишечной палочки
В октябре такое же пятно на том же месте появилось опять. Первые пару месяцев оно было размером – 1,5-2 см в диаметре. Но в конце декабря увеличилось раза в 2-2,5 и с тех пор постоянно постепенно увеличивается. Чешется, не постоянно и в основном терпимо; но бывает, что не выдерживаю и чешу его – тогда зуд проходит. Фото пятна на данный момент здесь:
http://firepic.org/images/2015-02/19/teud70gdvq0z.jpg
http://firepic.org/images/2015-02/19/fwzr8yi1vmeb.jpg
1.
В октябре – обращение к дерматологу. Сдала соскоб – пат. грибы не обнаружены. Назначен лоротадин – 10 дней – безрезультатно.
В ноябре – обращение к другому дерматологу. Рекомендована гидрокартизоновая мазь - тоже не помогала, мазала несколько раз – покраснение, зуд не снимала. Рекомендовано обращение к гастроэнтерологу.
2.
Декабрь - обращение к гастроэнтерологу:
1) общий анализ крови: гемоглобин – 90, эритроциты – 3,5 т/л, лейкоциты – 4,7 г/л, СОЭ - 8мм/ч, палочкоядерные – 3%, сегментоядерные – 45%, эозинофилы – 1%, лимфоциты – 42%, моноциты – 9%;
2)диагноз после ФГДС – рефлюкс гастрит;
3)прошла дуодональное зондирование – все в норме, лямблий не выявлено;
4) заключение УЗИ органов брюшной полости: признаки деформации желчного пузыря, застойных явлений в желчном пузыре, правостороннего нефроптоза, мочевого диатеза;
5) Сывороточное железо – 5,5;
6) дисбактериоз: кишечная палочка с измененными свойствами ферментов – 5*10 в 6 степени, enterobact – 3*10 в 6 степени. Пролечила Интетриксом – 1 капс/2р.д. – 10 дней, по окончанию интетрикса – хилак-форте – 10 дней. Сканкопии анализов до лечения дисбактериоза здесь:
http://firepic.org/images/2015-02/19/32ucw6ndwejw.png
и после:
http://firepic.org/images/2015-02/19/7nyf9oyw29tw.jpg
Остальные назначения гастроэнтеролога (принимала):
Домрид – 1 т/1 р.д – 10 дней
Мукоген – 1т/3 р.д. – 3 нед.
Панзинорм-форте – 1 р.д. – 7 дней.
3.
24 декабря – по рекомендации гастроэнтеролога – обращение к аллергологу:
1) имуноглобулин Е – 62,6;
2) имунологическое исследование здесь:
http://firepic.org/images/2015-02/19/8g9t03060rvo.png
http://firepic.org/images/2015-02/19/axlow0bfjy86.jpg
3) общий анализ крови: гемоглобин – 97, лейкоциты – 3,9 г/л, эритроциты – 4,54 т/л, СОЭ – 11 мм/ч, палочкоядерные – 3%, сегментоядерные – 60%, эозинофилы – 1%, лимфоциты – 30%, моноциты – 6%, тромбоциты – 72 г/л. Результат здесь:
http://firepic.org/images/2015-02/19/0et9uex8dez7.jpg
Заключение аллерголога: можно думать о грибковом поражении кожи. Рекомендовано повторное обращение к дерматологу, обращение к гематологу. Уверена, что это не аллергия.
4.
27 декабря – обращение к третьему дерматологу. При соскобе пат. Грибы не обнаружены. Врач уверен, что это не грибок, т.к. самостоятельно без лечения летом грибок полностью пройти не мог бы. К тому же за столь длительный срок он бы уже распространился по телу. Но тем не менее порекомендовал пробное лечение клотримазолом и люголем – пролечилась 7 дней с конца декабря до начала января.
5.
30 декабря – обращение к гематологу. Диагноз – железодефицитная анемия легкой степени. Назначен тардиферон (принимаю с начала января по 2 таб./д.). Направление из-за заниженных тромбоцитов (72 г/л) на анализы на ВИЧ, Гепатит В, С (не выявлено). Селезенка в норме.
6.
30 декабря – обращение к инфекционисту. По результатам гастроэнтерологических анализов и характера пятна, предположил, что это глистная инвазия. Принимала вармил – по 1т/3дня (2-4 января), гепабене, энтеросгель.
26 января – сдала контрольный анализ на дисбактериоз: -грибы рода Candida – 2*10 в 4 степени, Citrobacter – 3*10 в 6 степени . Результат здесь:
27 января – контрольный анализ крови – гемоглобин – 122, еритроциты – 4,1 г/л, эритроциты – 4,1 т/л, СОЭ – 3 мм/ч, палочкоядерные – 1%, сегментоядерные – 40%, эозинофилы – 2%, лимфоциты – 45%, моноциты – 12%, тромбоциты – 107 г/л. Результат здесь:
http://firepic.org/images/2015-02/19/74q5af65wdox.png
Пару недель назад тоже на шее чуть ниже большого пятна появилось новое маленькое (1-1,5 см) пятнышко такое же как первое, тоже чешется (его видно на фото).
Помогите мне, пожалуйста. Подскажите, в чем причина появления моих пятен? Как от них избавиться?
Заранее благодарна.
Мне 27 лет, женат 3 года, детей нет. До этого возраста ничем, кроме простуды не болел. 5 месяцев назад начали появляться боли в паху с повышением т. до 37,5. Через две недели я лег в стационар с температурой 38,5 и диагнозом острый серозный орхоэпидидимит с двух сторон. У супруги в уретре обнаружились: энтерококк, кишечная палочка. Меня лечили 2 недели 3-мя антибиотиками. После выписки через 3 дня по ночам сильно начали болеть ноги в области голеностопа, после правый сустав опух. в течении 3-х недель по ночам появлялись боли в поянице, в грудном отделе, голеностоп правый и температура 37,2. Через 2 месяца после выписки, боли остались в правом голеностопе и пояснице. При сидячем образе жизни боли усиливаются. При выписке из стационара все урологические анализы были в норме. По назначению принял курс вимово, аркоксии. Сдал анализ HLA-B27 - положительный. Один ревматолог диагностировала - недефференцированный спондилоартрит, другой - реактивный урогенный артрит (тенит правой стопы). МРТ - легко выраженные признаки сакроилеита с обеих сторон. принимаю: сульфасалазин, сердалуд мр, мовалис, мовалис, артрофоон + примочки на голеностоп.
Вопрос: Какому диагнозу верить, и каковы возможные последствия при одном из них?
Супруга прошла 3 курса антибиотиков, вылечили только кишечную палочку. Есть ли у меня вероятность заболеть снова при наличии у нее энтерококка?
Заранее большое спасибо!
Второе - положительный HLA-B27, особенно на фоне инфекции, лихорадки, может быть положительным. И в этом случае его трудно трактовать. Затем, умеренный сакроилеит на МРТ, - это факт, но лично мне очень бы хотелось увидеть обычные рентген-пленки крестцово-подвздошных сочленений. Кроме того, нужны количественные данные ревмопроб, и анализы крови, желательно развернутые, в динамике. Естественно, нужно пройти профосмотр (экг, флг и т.д.).
К сожалению, Вы не написали собственно вопрос. Но в Вашей ситуации целесообразно обратиться в клинику гастроэнтерологии и пройти полноценное целенаправленное обследование. Что касается замены колоноскопии на МРТ то при колоноскопии можно взять биопсию (при необходимости) и, возможно врач думал о данном исследовании.
Популярные статьи на тему: признаки кишечной палочки

Бартолинит – воспаление большой (бартолиновой) железы преддверия влагалища. Чаще всего это заболевание бывает односторонним и обычно вызывается различными микроорганизмами – гонококками, стафилококками, кишечной палочкой, трихомонадами и др.

Функциональные заболевания органов пищеварения (ФЗОП) относятся к наиболее распространенным заболеваниям человека. Суммарно признаки ФЗОП имеются почти у четверти населения земли и являются после респираторных инфекций второй причиной временной...

Вагинит - воспаление слизистой оболочки влагалища может вызываться различными возбудителями (грибками, кишечной палочкой, трихомонадами, гонококками, хламидиями и пр.) Насколько опасно заболевание и почему самолечение недопустимо читайте в нашей статье.

Вагинит – это воспаление слизистой оболочки влагалища. Данное заболевание является частым проявлением кандидоза, трихомониаза, гарднереллеза и др.

Дисбиоз – синдром при многих заболеваниях кишечника, при патологии тонкого кишечника характеризуется увеличением в нем количества микробных тел.

Синдром раздраженного кишечника (СРК) – функциональное заболевание, которое встречается у 10-45% населения земного шара. Такой большой разброс цифр обусловлен зачастую качеством диагностики и вообще уровнем медицинской помощи в стране, особенностями...

Проблемы рационального использования антибиотиков волнуют сегодня практически всех специалистов здравоохранения.

Пневмония – распространенное заболевание органов дыхания, встречающееся у 3-15 человек на 1000 населения.

В подавляющем большинстве случаев за абдоминальной болью, сочетающуюся с метеоризмом и различными расстройствами стула стоит синдром раздраженной кишки.
Новости на тему: признаки кишечной палочки
Власти Германии, которым и так не позавидуешь, попали в крайне неприятное положение – местные медики, наконец-то, обнаружили источник смертельно опасного штамма кишечной палочки – им оказалась обычная ферма на севере Германии. Испания очень гневается.

Человеку, далекому от науки, в это трудно поверить, но британские ученые – люди серьезные и рассчитывают, кроме всего прочего, и на коммерческий успех своего изобретения. С помощью методов генной инженерии они создали… «диагностический йогурт».

Помимо лечения человека, заболевшего туберкулезом, чрезвычайно важным является предупреждение заражения других людей, пребывавших в контакте с больным, особенно если болезнь у него протекает в активной форме. Новая методика определения формы заболевания позволит в кратчайшие сроки установить наличие у пациента исключительно заразной активной формы туберкулеза. Ранее такая проверка занимала недели, но американские ученые предложили проводить особый анализ крови, который сокращает время исследования до нескольких часов. Безусловно, внедрению нового метода будет предшествовать кропотливая дополнительная работа.









